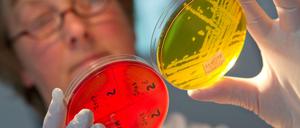
Saubere Forschung. Die Ergebnisse werden jedoch viel zu selten ernst genommen.

Der Grünen-Politiker Jürgen Trittin über russisches Erdgas, amerikanisches Fracking-Gas – und die Möglichkeit, auf beides zu verzichten. Ein Interview.

Der Grünen-Politiker Jürgen Trittin über russisches Erdgas, amerikanisches Fracking-Gas – und die Möglichkeit, auf beides zu verzichten. Ein Interview.

Lass kesseln: Mit „Werner - Wat Nu!?“ meldet sich ein Urgestein der deutschen Comicszene zurück.

Altkanzler Gerhard Schröder ist als Lobbyist für Nord Stream 2 umstritten. Jetzt verdächtigt er die USA, aus "eigensüchtigen Interessen" die Ostsee-Pipeline verhindern zu wollen.

Zwei der eindrucksvollsten Naturschutzgebiete der USA verlieren durch ein Dekret des Präsidenten massiv an Fläche. Naturschützer fürchten die Ausbeutung von Bodenschätzen.

Energiewende und Flüchtlingspolitik: Das sind dicke Knoten der Jamaika-Sondierungen. Mit Ideologie und Moral lassen sie sich nicht entwirren. Ein Kommentar.

Polen und Litauen kaufen amerikanisches Gas. Wie das die Geopolitik verändert - und Europa spalten könnte. Ein Kommentar.

Der Karriere hilft es selten: Was treibt Abgeordnete an, im Bundestag immer wieder gegen die eigene Fraktion zu stimmen?

Die Linken-Fraktionschefin Sahra Wagenknecht wirft SPD und Grünen vor, gar keinen Politikwechsel zu wollen und begründet, warum Donald Trump mit seiner Kritik an Deutschland recht hat.

Die Klimaentscheidung bestätigt: Die USA werden unter Präsident Donald Trump von einer Gestaltungs- zu einer Verhinderungsmacht. Ein Kommentar.

Um einen neuen Preisverfall zu verhindern, verlängert die Opec die Förderkürzung. Für Verbraucher ändert sich dadurch allerdings wenig: Benzin und Heizöl bleiben günstig.

Es ist eines der größten Naturreservate der Welt: das Selous in Tansania. Jetzt drohen Wilderei, Uranminen und ein Staudamm, die Region für immer zu zerstören. Wie können die Tiere und der Busch überleben?
Wissenschaftliche Ergebnisse sind so verfügbar wie nie - und dringen trotzdem nicht durch. Das fordert die Wissenschaft genauso wie den Journalismus. Ein Gastkommentar.

Weil Trump es so sagt: Wie Populisten erfolgreich ihre Deutung der Realität durchsetzen

Der künftige US-Präsident will das Pariser Abkommen kündigen und Obamas Politik rückgängig machen. Sein Übergangsteam besteht aus Klimawandelleugnern und Lobbyisten der Öl-, Gas- und Kohleindustrie.

Faszination, Ablehnung und Ekel ihm gegenüber gehen Hand in Hand. Trotzdem stimmen viele für ihn. Eine Erkundungsreise, durch Land und Geist, von Carmel Beach bis zur Road to Nirvana.

Die Zulassung von Glyphosat wird verlängert - es ist nur eine Gnadenfrist. Beim Fracking haben sich die schrillen Töne der Kampagnenführer bereits gegen die Wissenschaft durchgesetzt. Ein Kommentar.

Packing hört sich an wie Fracking, ist aber viel besser - und auch besser als das in die Jahre gekommene Pressing, meint unser Modewort-Experte.

Packing hört sich an wie Fracking, ist aber viel besser - und auch besser als das in die Jahre gekommene Pressing, meint unser Modewort-Experte.

Das Schauspielhaus Zürich beim Berliner Theatertreffen: Stefan Pucher und Dietmar Dath aktualisieren Ibsens „Volksfeind“.
Beim Thema TTIP sind Politikverdruss und Antiamerikanismus fast zum Selbstzweck geworden. Der Protest ist blind für die Vorteile: Das Handelsabkommen ist Europas Chance. Ein Essay.

Vivienne Westwood hebt sich mit ihrem Wesen und ihrem Stil seit jeher von anderen Designern ab. Heute wird sie 75 Jahre alt.

Im Frühjahr soll das umstrittene Fracking-Gesetz durch den Bundestag. Der Geophysiker Hans-Joachim Kümpel sieht das entspannt. Er sagt: Die Risiken sind beherrschbar.

Öl funktioniert am besten als Schmiermittel der Weltwirtschaft, wenn der Preis für die Förderländer und die Verbraucher verträglich ist.

Das Öl wird immer billiger und ist nun auf das Niveau der Finanzkrise 2009 gefallen. Was die Verbraucher freut, verschärft den Trend zur Deflation. Ein Kommentar.
Vivienne Westwood ist die einzige Designerin, die sich politisch äußert. Warum sich die Modebranche so zurückhält.

Der Terror verunsichert die Märkte, der IS verdient daran und vielerorts droht der Kollaps: So steht es momentan um das Erdöl.

In Ralph Dohrmanns neuem Roman lässt ein Einsiedler sich wieder auf das Leben ein. Er trifft dabei auf die Herausforderungen der technologischen Moderne - und, natürlich, die Liebe.

In der Provinz British Columbia in Kanada wurde ein Erdbeben der Stärke 4,4 gemessen. Offenbar hat es mit dem umstrittenen Fracking zu tun.

Der Vater wurde in der Schule noch geschlagen, wenn er seine Sprache nutzte. Clarence Louie über die Erfolge seines Stammes, Blutsbrüder und Schwitzhütten.

Wenn die Erde erzittert, ist das nicht immer das Werk der Natur. Auf der Suche nach Energie und Rohstoffen löst auch der Mensch Erschütterungen aus. Noch streiten Forscher, wie man sie vermeiden oder steuern kann.

Die große Koalition zieht ihren Gesetzentwurf zum Fracking vorläufig zurück. Der Streit dreht sich vor allem um eine Expertenkommission.

Fracking ist keine "Hochrisiko-Technologie", wie Umweltgruppen behaupten. Doch sachliche Argumente habe es in der Debatte schwer, wie auch die geplatzte Einigung zum Fracking-Gesetz zeigt. Ein Kommentar.

Wenn Wasser in die Erde gepumpt wird, um etwa Öl zu fördern oder Erdwärme zu nutzen, können Erdbeben ausgelöst werden. Warnzeichen helfen, Schäden zu verhindern.

Die Erdgasgewinnung mithilfe von Fracking ist heftig umstritten. Die Acatech, die Akademie der Technikwissenschaften, spricht sich nun in einer Stellungnahme gegen ein Verbot aus: Ein solches wäre wissenschaftlich nicht zu begründen.
Kanadischer Punk mit The Brat Attack und The Dead Peasants Revolt im Archiv

Können Forscher Politiker beeinflussen? Die schottische Biologin war die erste wissenschaftliche Beraterin der EU - bis sie einer Intrige zum Opfer fiel.

In Pennsylvania wurden in Wasserproben Chemikalien gefunden, die mutmaßlich von Gasbohrungen stammen. Nach Ansicht der Forscher war die Hülle der Bohrlöcher schadhaft. Die Industrie wiegelt ab.

Für die einen ist es eine gute Sache, für die anderen ein rotes Tuch: TTIP erhitzt seit Monaten die Gemüter. Nun sprechen sich große Energieunternehmen für die Angleichung technischer Standards auf beiden Seiten des Atlantiks aus.

Umweltaktivisten und die Schiefergas-Industrie geraten aneinander: Nichregierungsorganisation behaupten, dass einflussreiche Unternehmen eine wichtige Beratungsgruppe der EU-Kommission zur Fracking-Politik kontrollieren.

Nach Bohrungen in der Nähe des Flughafens London Gatwick wurde ein Ölfeld entdeckt, in dem 50 bis 100 Milliarden Barrel Öl liegen, ein Vielfaches der erwarteten Menge. Nur ein Bruchteil kann gefördert werden.
öffnet in neuem Tab oder Fenster